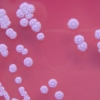
레지던트 이블?…美연구소, 위험 병원균 유출

-

신기록 경신한 자이언트 판다의 짝짓기 시간은?
2015-04-05 서울신문 -

암, 심장병 등 주요 질환, 아연 부족 영향 커 -美 연구
2015-03-30 나우뉴스 -

“저분자억제제로 암줄기세포 사멸효과 확인”
2015-03-30 서울신문 -
“술 하루 3잔 이상, 간암 위험 급증” -세계암연구기금
2015-03-30 나우뉴스 -

굴 먹으면 암·심장질환 등 막을 수 있어 -美 연구
2015-03-30 나우뉴스 -

목성서 초거대 ‘오로라 폭발’ 첫 포착…원인은 자전 탓
2015-03-29 나우뉴스 -
![[와우! 과학] NASA의 전기 비행기…프로펠러만 18개](https://imgnn.seoul.co.kr/img/upload/2015/03/27/SSI_20150327100506_S.jpg)
[와우! 과학] NASA의 전기 비행기…프로펠러만 18개
2015-03-27 나우뉴스 -
![[와우! 과학] 프로펠러가 무려 18개...NASA, 전기 비행기 개발](https://imgnn.seoul.co.kr/img/upload/2015/03/27/SSI_20150327100506_S.jpg)
[와우! 과학] 프로펠러가 무려 18개...NASA, 전기 비행기 개발
2015-03-27 나우뉴스 -

목성의 초거대 ‘오로라 폭발’ 포착…원인은 빠른 자전
2015-03-26 나우뉴스 -

대장암 치료 방해하는 새로운 유전자 찾아내
2015-03-18 서울신문 -

170년 전 난파선에서 발견한 맥주, 어떤 맛?
2015-03-09 나우뉴스 -

‘미세먼지’ 임신부 특히 조심을...기형아 위험↑
2015-03-02 나우뉴스 -
레지던트 이블?…美연구소, 위험 병원균 유출
2015-03-02 나우뉴스 -

암벽 오르고 달걀 집고...사람 의지대로 움직이는 ‘로봇 팔’ 화제
2015-02-27 나우뉴스 -

임신부 ‘미세먼지’ 마시지 마세요...기형아 출산 위험↑
2015-02-26 나우뉴스 -

미세먼지·대기오염, 기형아 출생 위험성 높인다
2015-02-26 나우뉴스 -
![[와우! 과학] 사하라 사막이 바다 건너 아마존숲 살린다](https://imgnn.seoul.co.kr/img/upload/2015/02/25/SSI_20150225142330_S.jpg)
[와우! 과학] 사하라 사막이 바다 건너 아마존숲 살린다
2015-02-25 나우뉴스 -
“PET검사로 유방암 재발 여부 확인한다”
2015-02-24 서울신문 -

이엘리서치, 다중지능검사는 행복 교육의 시작점
2015-02-23 서울신문 -
![[와우! 과학] ‘로봇 의수’로 암벽 등반도…상상이 현실되다](https://imgnn.seoul.co.kr/img/upload/2015/02/23/SSI_20150223104537_S.jpg)
[와우! 과학] ‘로봇 의수’로 암벽 등반도…상상이 현실되다
2015-02-23 나우뉴스 -

줄기세포 모발 이식…‘탈모 치료의 꿈’ 이뤄질까?
2015-02-01 나우뉴스 -
![[와우! 과학] 지구 온난화가 아이슬란드를 들어 올렸다?](https://imgnn.seoul.co.kr/img/upload/2015/02/01/SSI_20150201154001_S.jpg)
[와우! 과학] 지구 온난화가 아이슬란드를 들어 올렸다?
2015-02-01 나우뉴스 -

남극 빙붕 아래 ‘반투명 물고기’ 사상 첫 포착
2015-01-31 나우뉴스 -

남극 빙상 아래 사는 희귀 물고기 사상 첫 포착
2015-01-25 나우뉴스 -

남극 빙상 800m 아래에 사는 희귀 물고기 첫 포착
2015-01-22 나우뉴스 -

남극 빙상 800m 아래에 사는 물고기 사상 첫 포착
2015-01-22 나우뉴스 -

“SNS 사용 여성, 오히려 스트레스 지수 낮다”
2015-01-16 나우뉴스 -
![[기획] 北, 막강 위력 ‘최신형 수호이 전투기’ 도입할까](https://imgnn.seoul.co.kr/img/upload/2015/01/13/SSI_20150113173324_S.jpg)
[기획] 北, 막강 위력 ‘최신형 수호이 전투기’ 도입할까
2015-01-14 나우뉴스 -
![[이일우의 밀리터리 talk] 北, ‘최신형 수호이 전투기’ 도입하나](https://imgnn.seoul.co.kr/img/upload/2015/01/13/SSI_20150113173324_S.jpg)
[이일우의 밀리터리 talk] 北, ‘최신형 수호이 전투기’ 도입하나
2015-01-13 나우뉴스 -
“소의 초유, 인체 면역력 증진에 도움”
2014-12-22 서울신문


